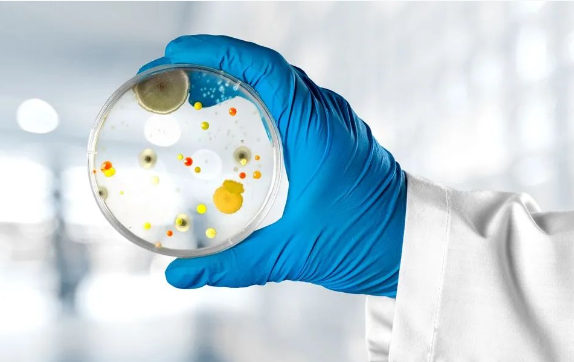

TECHNICAL COLUMN
學(xué)習(xí)資源當(dāng)前位置:首頁 > 學(xué)習(xí)資源
倫敦瑪麗皇后大學(xué)精密醫(yī)療研究所(PHURI)和柏林健康研究所(BIH)的研究人員已經(jīng)確定了雷諾綜合征的遺傳原因。他們的研究結(jié)果發(fā)表在今天的《自然通訊》雜志上,可能會為雷諾氏癥患者帶來第一個有效的治療方法。

韓國研究人員發(fā)現(xiàn)了一種新的信號通路,可以促進(jìn)與衰老有關(guān)的慢性代謝疾病。

弗吉尼亞大學(xué)醫(yī)學(xué)院的研究人員發(fā)現(xiàn)了慢性炎癥加速衰老的關(guān)鍵驅(qū)動因素。這一發(fā)現(xiàn)可以讓我們放慢時鐘的速度,活得更長、更健康,并可能讓我們預(yù)防與年齡有關(guān)的疾病
研究人員發(fā)現(xiàn)了一種以前未知的機制,細(xì)菌通過噬菌體分享它們的遺傳物質(zhì)。這些見解可以幫助科學(xué)家更好地了解細(xì)菌是如何快速適應(yīng)和進(jìn)化的,以及它們是如何變得更具毒性和對抗生素具有耐藥性的。

研究人員的方法使用了擴增的多能干細(xì)胞(EPSCs),而不是更常用的引物多能干細(xì)胞。這些細(xì)胞在小鼠體內(nèi)分化為胚胎組織和胚胎外組織。通過向人類EPSCs中添加適當(dāng)?shù)纳L因子,它們分化為這兩種類型的組織。


口外苦味感受器也可以作為膽汁酸的內(nèi)源性傳感器。這一發(fā)現(xiàn)表明,除了食物成分外,內(nèi)源性物質(zhì)也可能影響苦味感受器的進(jìn)化。

根據(jù)最近的研究,對一種與腎臟和心臟損傷有關(guān)的蛋白質(zhì)的新認(rèn)識可能為慢性腎臟疾病的新治療策略鋪平道路。

從影響我們身體儲存脂肪的方式到大腦調(diào)節(jié)食欲的方式,數(shù)百種基因以及環(huán)境因素共同決定了我們的體重和體型。

一個國際研究小組對世界上第一個馴化作物:單粒小麥(einkorn wheat)的完整基因組進(jìn)行了測序,并追蹤了它的進(jìn)化歷史。這些信息將幫助研究人員識別耐病、耐旱和耐熱等遺傳特征

由牛津大學(xué)領(lǐng)導(dǎo)的一組科學(xué)家在檢測蛋白質(zhì)結(jié)構(gòu)變化方面取得了重大突破。

一項新的快速測試表明,通過追蹤白細(xì)胞的蛋白質(zhì)特征,可以快速準(zhǔn)確地識別出嗜酸性粒細(xì)胞,即使它們存在于痰等復(fù)雜的生物樣本中。


微信掃碼在線客服